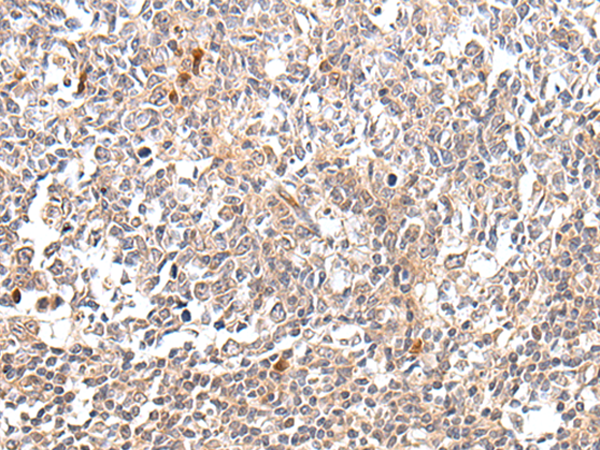
一抗

中文名稱: 兔抗DDIT3多克隆抗體
|
Background: |
This gene encodes a member of the CCAAT/enhancer-binding protein (C/EBP) family of transcription factors. The protein functions as a dominant-negative inhibitor by forming heterodimers with other C/EBP members, such as C/EBP and LAP (liver activator protein), and preventing their DNA binding activity. The protein is implicated in adipogenesis and erythropoiesis, is activated by endoplasmic reticulum stress, and promotes apoptosis. Fusion of this gene and FUS on chromosome 16 or EWSR1 on chromosome 22 induced by translocation generates chimeric proteins in myxoid liposarcomas or Ewing sarcoma. Multiple alternatively spliced transcript variants encoding two isoforms with different length have been identified. |
|
Applications: |
ELISA, IHC |
|
Name of antibody: |
DDIT3 |
|
Immunogen: |
Synthetic peptide of human DDIT3 |
|
Full name: |
DNA-damage-inducible transcript 3 |
|
Synonyms: |
CHOP; CEBPZ; CHOP10; CHOP-10; GADD153 |
|
SwissProt: |
P35638 |
|
ELISA Recommended dilution: |
5000-10000 |
|
IHC positive control: |
Human tonsil |
|
IHC Recommend dilution: |
25-100 |

 購(gòu)物車
購(gòu)物車 幫助
幫助
 021-54845833/15800441009
021-54845833/15800441009